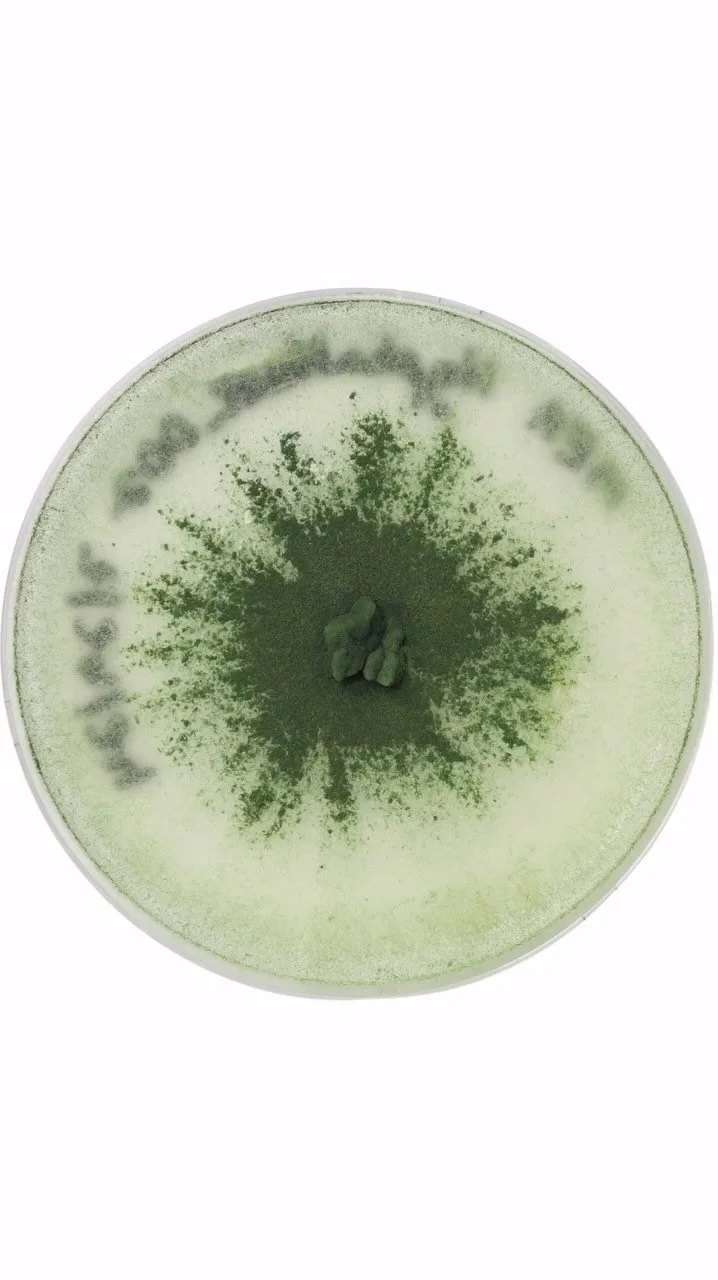

Symbiiotica is an eco-educational platform offering various pathways of engagement with our interspecies relations. We provide spaces where teachings in ecology, mycology, mushroom cultivation, herbalism and more can be accessed and integrated.
PAST & PRESENT EVENTS
CULTIVATION CONSULTATIONS
FUNGAL ID & ECOLOGY WALKS
WELLNESS
CLASSES & WORKSHOPS
ART